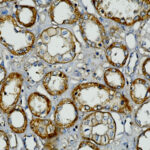

|
|---|
 Anti-CD11b/ITAM Anti-CD11b/ITAMBuy here |
 Anti-CD11c Anti-CD11cBuy here |
 Anti-CD123 (IL3RA), Clone IL3RA/1531 Anti-CD123 (IL3RA), Clone IL3RA/1531Buy here |
 Anti-CD13 Anti-CD13Buy here |
 Anti-CD133 Anti-CD133Buy here |
 Anti-CD137, Clone BBK-2 Anti-CD137, Clone BBK-2Buy here |
 Anti-CD138 Anti-CD138Buy here |
 Anti-CD14 Anti-CD14Buy here |
 Anti-CD146 Anti-CD146Buy here |
 Anti-CD147, Clone BSG/963 Anti-CD147, Clone BSG/963Buy here |